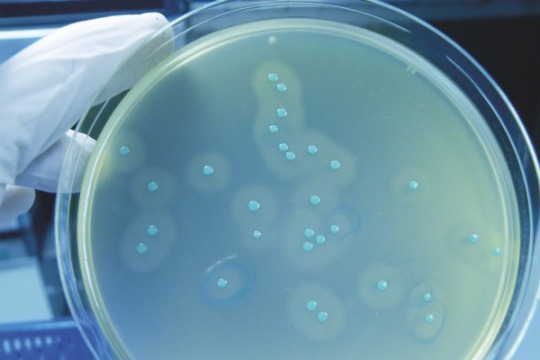

Norwegian Seafood versterkt listeriapreventie met LoopiX

Webinar: Managing & Controlling Biofilms
Hoe herken je biofilm in de productieomgeving en hoe kun je biofilms beheersen? Tijdens ons internationale webinar bieden we professionals in de voedingsindustrie praktische inzichten in het ontstaan, herkennen en beheersen van biofilms. Experts delen wetenschappelijke kennis en bewezen methoden om microbiologische risico’s te minimaliseren. Meld je aan!

Dienstverlening feestdagen
Bekijk ons aangepaste leveringsschema rond kerst en oud en nieuw. Wij wensen u alvast fijne dagen!

Wasmiddelen voor de Sheltersuit Foundation
Bij Christeyns geloven we in de kracht van samenwerking om echte impact te maken. Daarom steunen we sinds kort de Sheltersuit Foundation, een bijzondere organisatie die water- en winddichte jassen met afritsbare slaapzak maakt voor mensen die dak- of thuisloos zijn. Deze Sheltersuits worden volledig geupcycled van restmateriaal uit de textielindustrie en worden vervaardigd in […]

Christeyns met Rapid-O op Recreatie Vakbeurs 2025
Op 11, 12 en 13 november is Christeyns Professional Hygiene aanwezig op de Recreatie Vakbeurs in de Evenementenhal in Hardenberg. Tijdens deze dagen presenteren we innovatieve hygiëneoplossingen voor de recreatiebranche, waaronder het unieke Rapid-O wasconcept.
Webinar: Total Listeria Management
Op 3 september organiseert Christeyns Food Hygiene een gratis Engelstalig webinar over Listeria management. Internationale experts delen hun inzichten over detectie, reiniging, training en effectieve hygiëneplannen. Ontdek hoe u uw strategie voor voedselveiligheid kunt versterken.

Ons MVO-verslag 2024 is gepubliceerd
Met trots kondigen we de publicatie aan van ons MVO-verslag over 2024. Hoewel dit niet ons eerste verslag is, hebben we het met dezelfde passie en toewijding gemaakt. In dit verslag belichten we de belangrijkste initiatieven, acties en mijlpalen die we het afgelopen jaar samen hebben bereikt – als bedrijf én als hechte familie van […]

Leveringen rond de NAVO-top
In de week van de NAVO-top zijn verschillende hoofdwegen in de regio afgesloten of beperkt toegankelijk. Lees welke gevolgen dit heeft voor de levering van onze producten.

Christeyns en Klaratex: innovatie en duurzaamheid hand in hand
Christeyns en Klaratex werken al decennia lang samen en hebben een partnership opgebouwd waarbij innovatie en duurzaamheid hand in hand gaan. Innovaties hebben bijgedragen aan een efficiënter en milieuvriendelijker wasproces, het installeren van HydRO heeft er zelfs toe geleid dat Klaratex 80% van het afvalwater hergebruikt.

Bezoek Christeyns op Food Tech Event 2025
Bezoek Christeyns Food Hygiene op 14 en 15 mei op Food Tech Event 2025 in de Brabanthallen in Den Bosch. We zien je graag in onze stand, nummer 119.

Dienstverlening feestdagen voorjaar
In april, mei en juni vieren we diverse feestdagen. Bekijk alle details over onze aangepaste dienstverlening en plan de orders op tijd in. Wij wensen u alvast fijne en zonnige feestdagen!

Christeyns wint wasserij aanbesteding Dienst Justitiële Inrichtingen
Met trots mogen we aankondigen dat Christeyns Professional Hygiene de aanbesteding van de Dienst Justitiële Inrichtingen (DJI) voor de wasserij heeft gewonnen! Dat betekent dat we de komende periode verantwoordelijk zijn voor de levering van wasmiddelen, hulpchemicaliën en doseerapparatuur voor drie landelijke wasserijen van DJI. De betreffende wasserijen zijn gevestigd in Penitentiaire Inrichting Veenhuizen – […]

366 marathons in 366 dagen: onze collega Hilde Dosogne over haar wereldrecord
Collega Hilde Dosogne, Sr. Regulatory Affairs Manager op ons hoofdkantoor in Gent, vestigde een (momenteel nog officieus) wereldrecord met 366 opeenvolgende marathons in 2024. We wilden haar graag persoonlijk feliciteren en horen hoe het nu met haar gaat. Van harte gefeliciteerd met deze uitzonderlijke prestatie. Wat een krachtinspanning! Hoe gaat het nu met je? Hilde: […]
